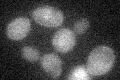
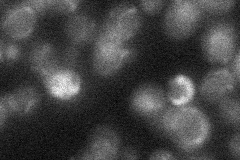

View description
Origin-binding F-box protein that forms an SCF ubiquitin ligase complex with Skp1p and Cdc53p; plays a role in DNA replication, involved in invasive and pseudohyphal growth
Localization:
Intensity:
Fold change:
Significance:
-
C’ GFP library in SD
below threshold15.74 -
N' NOP1pr-GFP in SD

nucleus31.2485 -
N' TEF2pr-mCherry in SD

nucleus19.6387 -
N' NATIVEpr-GFP in SD
below threshold17.3538 -
N' TEF2pr-VC and Cyto-VN in SD

#N/A0 -
C’ GFP library in SD+DTT

cytosol18.111.15No -
C’ GFP library in SD+H2O2

cytosol20.591.3No -
C’ GFP library in Starvation Media

cytosol15.50.98No -
C’ GFP library on the background of Pup2-DaMP

below threshold -
C’ GFP library on the background of CCT mutant

below threshold16.96271.07738No
